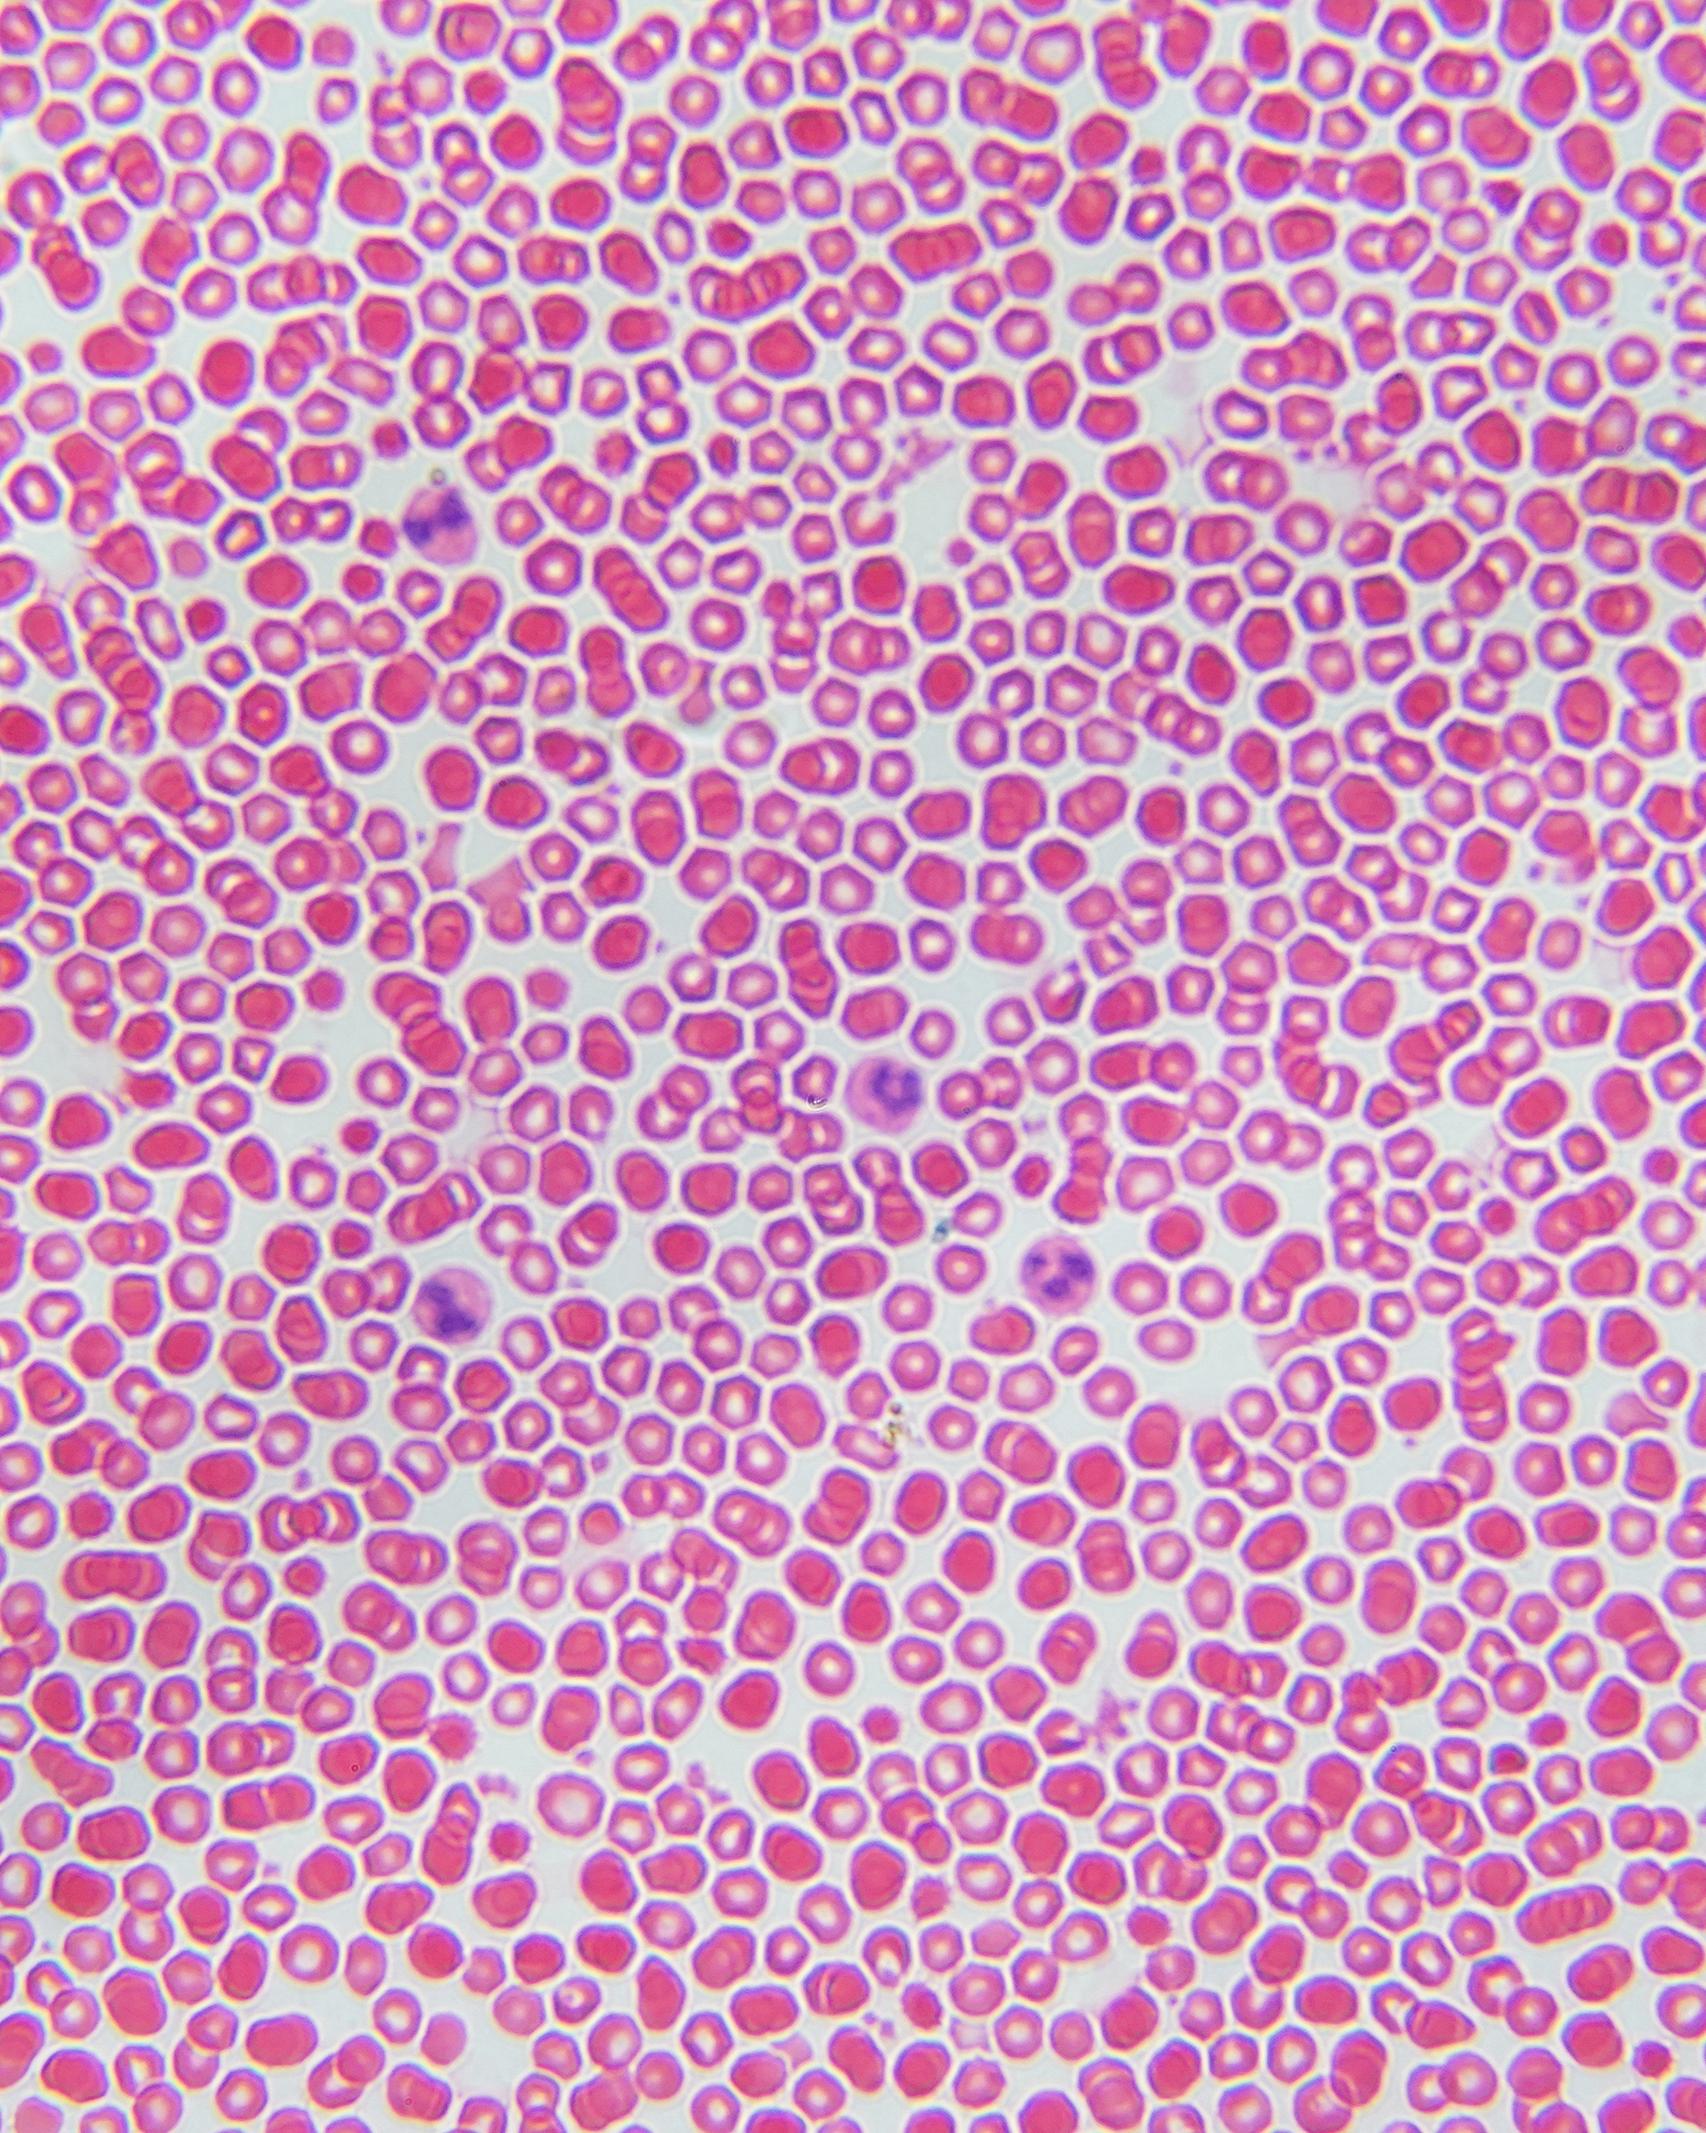
microscopic view of pink and red blood cells

Program details
This research-based master's degree is offered through the Cornell Graduate School in the Graduate Field of Nutrition. As a student, you'll have access to all the resources of the graduate school in addition to direct connections to the faculty in the Division of Nutritional Sciences (DNS).
Master's students are required to complete 60 credits, typically 15 credits a semester for four semesters. The summer between first and second year is dedicated to research.

Choose your track
The program is flexible. You can choose between two defined tracks, or create your own course of study.
If you’d prefer to structure your own program based on your specific interests and ambitions, the individualized track is for you.
Drawing on a wealth of expertise from the largest faculty in the country devoted to the study of human nutrition, you will discover your opportunity to make an impact.
Included among our faculty are specialists in biochemical, metabolic, epidemiological and socio-cultural research, with expertise in:
- nutrition for maternal and child health
- nutrition for metabolic health
- nutrition for precision health
This track will prepare you for work that focuses on global and public health issues both domestically and internationally.
Our faculty work on community-based programs and interventions, epidemiology, food and nutrition security, poverty and malnutrition, and economic factors related to nutrition.
Courses build off of foundational nutrition metabolism and include public health nutrition, nutrition and health equity, maternal and child nutrition, epidemiology and translational research and evidence.
The M.S. + Dietetics track will prepare you for evidence-based practice as a Registered Dietitian Nutritionist (RDN) in community, clinical and management settings — or for leadership or research roles within a practice.
This track incorporates the Cornell Dietetic Internship (DI) into the two-year M.S. program. To be eligible for the M.S. + Dietetics track, applicants must have completed or be completing (by the start of the internship) an ACEND-accredited Didactic Program in Dietetics (DPD). Find application instructions, accreditation information, and eligibility details on the DI website.
Faculty you'll work with













Associate Dean for CHE in NYC











Contact us
Email DNS graduate student services with questions or for further information.
